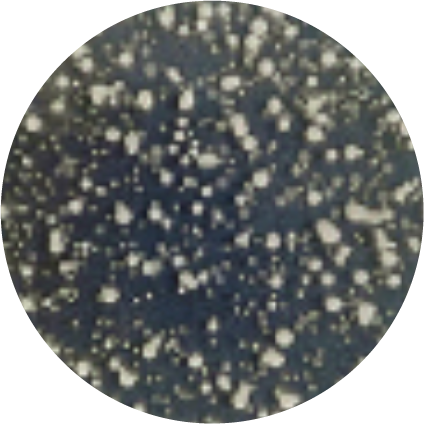
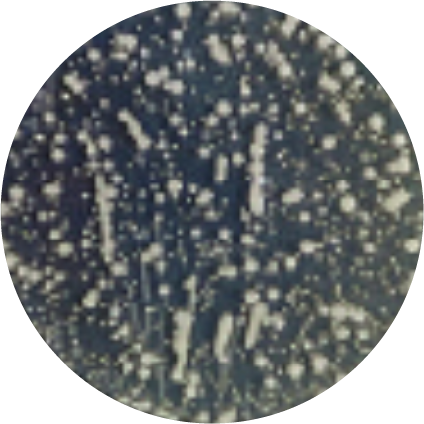
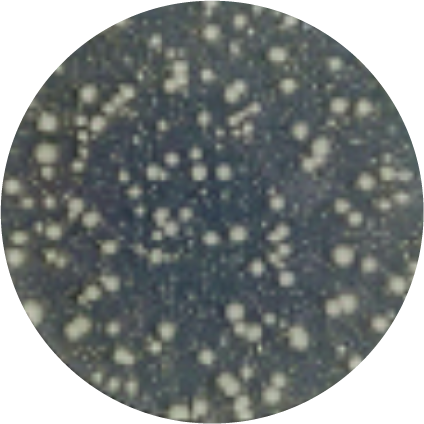
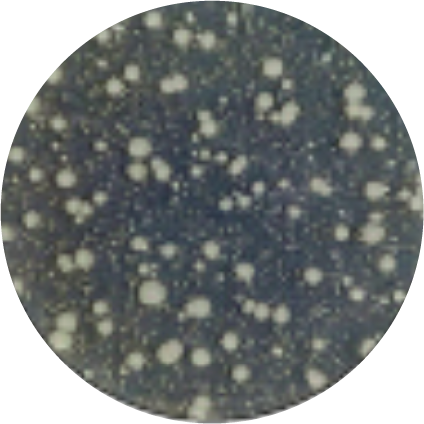
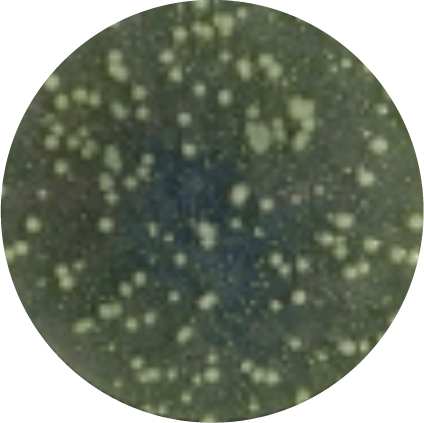
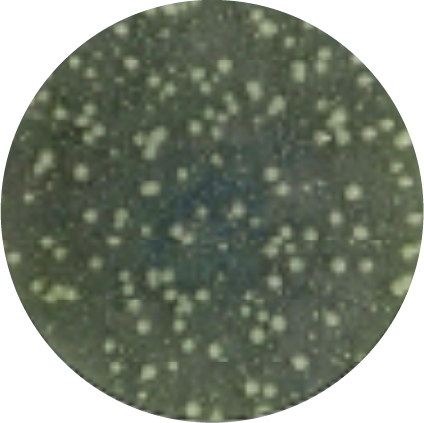

試験データ FUNCTIONAL TEST RESULTS
ハイブリッド触媒® Tio Tio® PREMIUM
試験データのご案内
ハイブリッド触媒® TioTio® PREMIUM 加工/ティオ・ティオ プレミアム加工は、大阪大学産業科学研究所との連携研究契約によって生まれた多機能型触媒を使用した加工です。清潔で健康な暮らしを望む皆様のご要望に応える新たな加工技術として大きな注目を集めています。お肌に優しく敏感肌の方にも安心してご使用いただけます。



試験データFunctional test results
抗菌性試験
(試験方法:JIS L 1902)
黄色ブドウ球菌
一般財団法人ボーケン品質評価機構
試験番号 20221030562-1
加工布 洗濯50回後

- 19,000個
- 接種直後

- 20個以下
- 18時間後
99.89%以上減少
(抗菌活性値 5.90)
未加工布

- 27,000個
- 接種直後

- 1,600万個
- 18時間後
590倍に増殖
肺炎桿菌
試験番号 20221030563-1
加工布 洗濯50回後
- 20,000個
- 接種直後

- 20個以下
- 18時間後
99.90%以上減少
(抗菌活性値 6.10)
未加工布
- 25,000個
- 接種直後

- 2,400万個
- 18時間後
960倍に増殖
MRSA
試験番号 20221030564-1
加工布 洗濯50回後

- 19,000個
- 接種直後

- 20個以下
- 18時間後
99.42%以上減少
(抗菌活性値 5.00)
未加工布

- 23,000個
- 接種直後

- 1,200万個
- 18時間後
520倍に増殖
大腸菌
試験番号 20221030566-1
加工布 洗濯50回後
- 19,000個
- 接種直後

- 20個以下
- 18時間後
99.89%以上減少
(抗菌活性値 6.30)
未加工布
- 25,000個
- 接種直後

- 3,800万個
- 18時間後
1,520倍に増殖
緑膿菌
試験番号 20221031126-1
加工布 洗濯50回後
- 18,000個
- 接種直後

- 1,280個以下
- 18時間後
92.88%以上減少
(抗菌活性値 4.10)
未加工布
- 27,000個
- 接種直後

- 1,600万個
- 18時間後
590倍に増殖
モラクセラ菌
試験番号 20221030567-1
加工布 洗濯50回後

- 17,000個
- 接種直後

- 20個以下
- 18時間後
99.88%以上減少
(抗菌活性値 6.20)
未加工布

- 25,000個
- 接種直後

- 3,400万個
- 18時間後
1,360倍に増殖
加工布18時間後は、菌が殆ど無いため、培養床カンテンの色そのもので、画像では無地に見えます。
未加工布18時間後は、菌が爆発的に増殖したため、菌の密度が上がり過ぎ埋め尽くされ、画像では無地に見えます。
消臭試験
一般財団法人ボーケン品質評価機構
試験番号 20221027267-1/20221031497-1/20221054121-1
(試験方法:一般社団法人 繊維評価技術協議会 SEKマーク繊維製品認証基準 検知管法、ガスクロマトグラフ法)
| 成分名 | 初発濃度 | 洗濯0回 (2時間後 減少率) |
洗濯50回後 (2時間後 減少率) |
|---|---|---|---|
| アンモニア | 100ppm |
≧99% |
≧99% |
| 酢酸 | 30ppm |
98% |
99% |
| イソ吉草酸 | 約38ppm |
99% |
≧99% |
| ノネナール | 約14ppm |
91% |
85% |
| ホルムアルデヒド | 15ppm |
≧99% |
97% |
| 硫化水素 | 4ppm |
≧99% |
≧99% |
| メチルメルカプタン | 8ppm |
99% |
99% |
| トリメチルアミン | 28ppm |
≧99% |
93% |
| ピリジン | 12ppm |
91% |
73% |
| インドール | 約33ppm |
96% |
94% |
| アセトアルデヒド ※1アセトアルデヒドのみ洗濯10回後 |
14ppm |
99% |
99% |
抗ウイルス性試験
一般財団法人ボーケン品質評価機構
試験番号 20221049475-1
(試験方法:JIS L 1922)
| 試験ウイルス株 | ATCC VR-1679(エンベロープ有) | ATCC VR-782(エンベロープ無) | ||
|---|---|---|---|---|
| 抗ウイルス活性値 | 洗濯0回 4.5 | 洗濯10回 4.1 | 洗濯0回 4.4 | 洗濯10回 4.4 |
- 繊維上の特定のウイルスの数を減少させます。
- 抗ウイルス加工は、病気の治療や予防を目的とするものではありません。
- 抗ウイルス性試験は、ウイルス株を25℃で2時間放置して実施しています。
- 抗ウイルス加工は、ウイルスの働きを抑制するものではありません。
新型コロナウイルス 抗ウイルス性試験
一般財団法人日本繊維製品品質技術センター(QTEC)
(試験方法:JIS L 1922 準用)
抗かび性試験
一般財団法人ボーケン品質評価機構
(試験方法:JIS L 1921:2015[吸収法])
試験番号 20221049764-1/20221049763-1
| かびの種類 | クロカビ | 白癬菌 | ||
|---|---|---|---|---|
| 抗かび活性値 | 洗濯0回 3.1 | 洗濯10回 2.1 | 洗濯0回 3.0 | 洗濯10回 2.0 |
試験番号 20221027269-1
| かびの種類 | アオカビ | クロコウジカビ | ||
|---|---|---|---|---|
| 抗かび活性値 | 洗濯0回 3.2 | 洗濯10回 2.4 | 洗濯0回 3.3 | 洗濯10回 2.0 |
- 抗かび加工は、病気の治療や予防の効果はありません。
- 抗かび加工は、かびを死滅させるものではありません。
- 試験実施のかび以外の抗かび性は確認していません。
- 抗かび加工製品でも高温・多湿の状態で放置すると、かびが発生しやすくなります。
かび抵抗性試験
一般財団法人ボーケン品質評価機構
(試験方法:JIS Z 2911:2018[湿式法])
試験番号 20221027268-1
| 洗濯回数 | かびの生育 | かび抵抗性 表示 |
|||
|---|---|---|---|---|---|
| 4日 | 7日 | 10日 | 14日 | ||
| 0回 | ー | ー | ー | ー | 0 |
| 10回 | ー | ー | ー | ー | 0 |
試験菌株 下記4菌株の混合胞子懸濁液を噴霧した。
- 黒麹かびAspergillus niger NBRC 105649(クロコウジカビ) (アスペルギルス ニゲル)
- 青かびPenicillium citrinum NBRC 6352(アオカビ種) (ペニシリウム シトリナム)
- ケトミウムChaetomium globosum NBRC 6347 (ケタマカビ種) (ケトミウム グロボスム)
- ミロテシウムMyrothecium verrucaria NBRC 6113(クワ暗斑病菌種) (ミロテシウム ベルカリア)
※表中(ー)
かびの生育を認めない
(+)~(+++)
※表示
帯電性試験
一般財団法人ボーケン品質評価機構
(試験方法:JIS L 1094)
試験番号 20221053055-1
| 試験方法 | ポリエステル100%生地 TioTio®PREMIUM加工品 |
ポリエステル100%生地 未加工品 |
|||
|---|---|---|---|---|---|
| 帯電性(S) | JIS-L-1094 半滅期20℃×40% |
1.0未満 | 91 | ||
| 帯電性(V) | JIS-L-1094 摩擦帯電圧測定法 20℃×40% |
開始1分後 | 開始1分後 | ||
| 摩擦布:綿 | 摩擦布:綿 | ||||
| たて | 1.3 | たて | 5100 | ||
| よこ | 1.3 | よこ | 4300 | ||
| 摩擦布:毛 | 摩擦布:毛 | ||||
| たて | 1.0 | たて | 5400 | ||
| よこ | 1.0 | よこ | 5600 | ||
触媒加工固着イメージAdherence to surfaces
ハイブリッド触媒®TioTio®PREMIUM(ティオティオ プレミアム)加工された繊維素材の加工表面
ハイブリッド触媒®固着画像①(900倍)
走査型電子顕微鏡(SEM)による表面形状
加工前

素材:ポリエステル100% 生地
ハイブリッド触媒®固着画像②(10,000倍)
走査型電子顕微鏡(SEM)による表面形状
加工前

素材:ポリエステル100% 生地
ハイブリッド触媒®による、加工前と加工後の固着状態の様子です。カラー画像では鮮明度をアップし、触媒部分が加工面を覆うように固着している様子がわかります。(赤い斑点部分)







